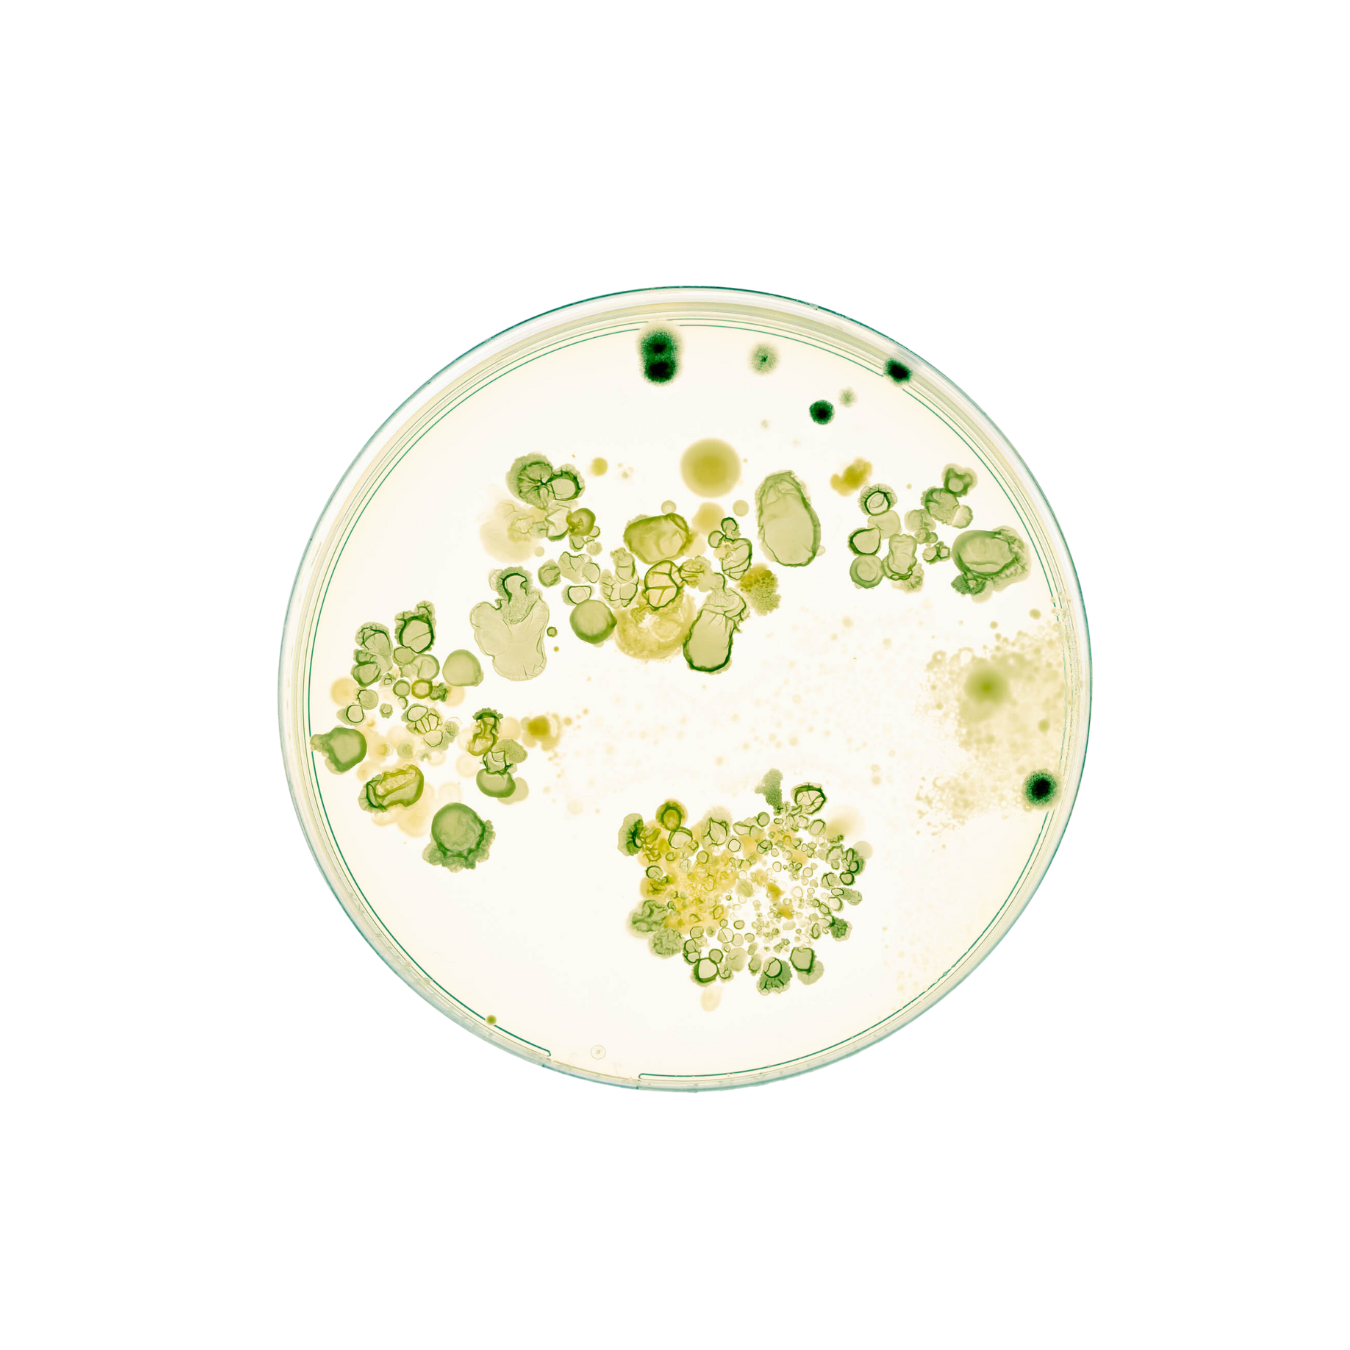

1-011 TÓNICO CALMA
BIO TECNOLÓGICO + AMINOÁCIDOS + ENZIMAS — Gracias a las células madre vegetales Sensia Carota, este tónico ayuda a calmar, hidratar y proteger la piel sensible, reduciendo el enrojecimiento y reequilibrando la microbiota, ayudando a restablecer el bienestar de las células epidérmicas.
✔️ El 91% de los clientes compran 2 o más.
- Compra segura y protegida
- Envío gratuito (Desde 50€/ España y 100€/ worldwide)
- Packaging sostenible y biodegradable
- Envío en 24/ 48 horas
Beneficios
Principios activos
Modos de uso
Elige opciones






Todo lo que necesitas saber
1-011 TÓNICO CALMA
by Eli (founder Mamita Botanical)
Ingredientes destacados
CÉLULA MADRE DE SENSIA CAROTA
Alivio para la piel sensible, combate la inflamación latente. Formulado para obtener biotecnológicamente un ingrediente multi-activo frente los agresores ambientales y químicos que amenazan la piel diariamente.
AGUA DE COCO
Repleta de aminoácidos, enzimas, antioxidantes, fitonutrientes y citoquininas, hormonas vegetales que brindan beneficios contra el envejecimiento cutáneo ya que ralentizan el deterioro de los tejidos. Aporta hidratación natural.
AGUA DE ROSAS
Contiene vitamina B, C y E que ayuda a suavizar, hidratar y combatir la oxidación. Estimula la producción de colágeno. Relaja y calma la piel.

VEGAN, CRUELTY FREE & NO HARMFUL CHEMICAL INGREDIENTS


MANUELA
27/ 04/ 23


25%
Protege la piel sensible del aumento de la rojez y lo disminuye al 25%
101%
Aumenta el bienestar de las células epidérmicas
39%
Reduce hasta el 39% de la inflamación cutánea tras 24h de uso.
38%
Reducción frente el estrés oxidativo en la piel
25%
Protege la piel sensible del aumento de la rojez y lo disminuye al 25%
101%
Aumenta el bienestar de las células epidérmicas
39%
Reduce hasta el 39% de la inflamación cutánea tras 24h de uso.
38%
Reducción frente el estrés oxidativo en la piel
TODO LO QUE LLEVA ES TAN IMPORTANTE COMO LO QUE NO

Nuestro manifiesto
El estado de nuestra piel no es permanente, responde a habitos, emociones, clima, alimentación y productos que pongamos sobre ella o en el ambiente. En MAMITA BOTANICAL SKINCARE ofrecemos un cuidado integral, por eso acercamos el RITUAL a tu ritmo de vida y te acompañamos según en el momento en el que estás. Todos nuestros productos formulados con la más alta gama de principos activos naturales, estimulan la regeneración celular y ayudan a reparar tejidos ofreciendo resultados visibles.